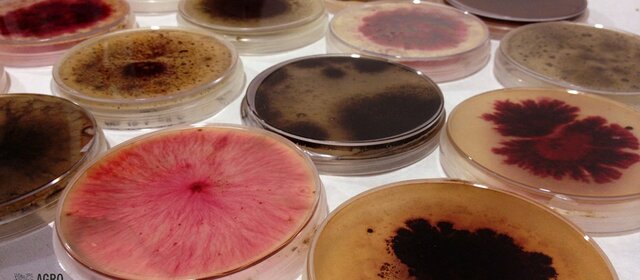
Primera colección de bacterias y hongos
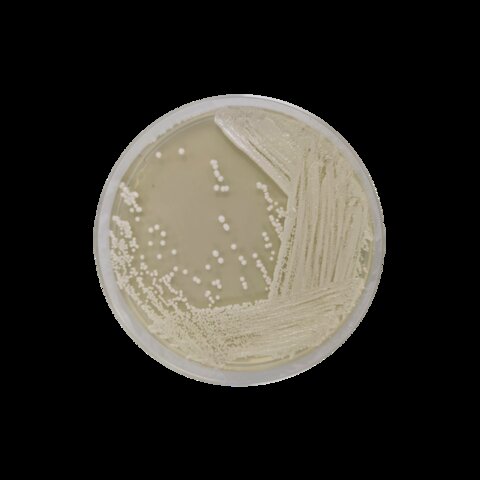
Cultivos puros

-
 Observa animalículos en agua y cerveza
Observa animalículos en agua y cerveza -
 Propone que el alcohol es producido por bacterias
Propone que el alcohol es producido por bacterias -
 La producción en el proceso de fermentación de ciertos ácidos era debida a la acción de microorganismos como las bacterias
La producción en el proceso de fermentación de ciertos ácidos era debida a la acción de microorganismos como las bacterias -
 Pionero en técnicas de cultivo de hongos. Emplea gelatina para solidificar los medios (cultivo monospórico).
Pionero en técnicas de cultivo de hongos. Emplea gelatina para solidificar los medios (cultivo monospórico). -
 Robert Koch le incorpora agar al Caldo nutritivo de Loeffler
Robert Koch le incorpora agar al Caldo nutritivo de Loeffler -
 Hansen desarrolla la técnica del cultivo puro con levaduras
Hansen desarrolla la técnica del cultivo puro con levaduras -
Frantisek Kral genera la primera colección de bacterias y hongos
Frantisek Kral genera la primera colección de bacterias y hongos
en Praga. Cepas de Mycobacterium (Koch). Cierra en 1911 y se pierden las cepas -
Cultivos puros de bacterias y levaduras de mantienen en medios sólidos a base de caldo nutritivo y extracto de malta y se propagan
Cultivos puros de bacterias y levaduras de mantienen en medios sólidos a base de caldo nutritivo y extracto de malta y se propagan
periódicamente. Se requiere conservación a largo plazo para preservar las características de los cultivos -
 Se publica el primer catálogo de cepas de hongos de la
Se publica el primer catálogo de cepas de hongos de la
International Botany Association. Es el antecesor del CBS (Centraal Bureau voor Schimmelcultures) -
 Will preserva levaduras en 10 % sacarosa durante 8 años, pero hay pérdida de actividad
Will preserva levaduras en 10 % sacarosa durante 8 años, pero hay pérdida de actividad -
 Shackel; Hammer: primeros métodos de liofilización para bacterias y
Shackel; Hammer: primeros métodos de liofilización para bacterias y
virus, empleo de suero y leche como protectores -
 Colección de bacterias en el National History Museum of New
Colección de bacterias en el National History Museum of New
York City. Es el antecesor del ATCC (American Type Culture Collection) -
 Lumiere y Cherrotier conserva cultivos de Gonococcus bajo una capa de parafina líquida, el método es perfeccionado por Morton y Pulski (1938)
Lumiere y Cherrotier conserva cultivos de Gonococcus bajo una capa de parafina líquida, el método es perfeccionado por Morton y Pulski (1938) -
 Takeda Chemical Industries, Ltd. funda el Institute for Aerial
Takeda Chemical Industries, Ltd. funda el Institute for Aerial
Fermentation para aislar, conservar y distribuir microorganismos, es el antecesor del Institute for Fermentation (IFO, Osaka) -
 La producción industrial de antibióticos estimula el desarrollo de nuevas técnicas. Liofilización, crio-conservación, adsorción en suelo, etc; permite el mantenimiento de cultivos por 10 o 20 años.
La producción industrial de antibióticos estimula el desarrollo de nuevas técnicas. Liofilización, crio-conservación, adsorción en suelo, etc; permite el mantenimiento de cultivos por 10 o 20 años. -
 Se descubre el efecto crioprotector de varios compuestos: glicerol,
Se descubre el efecto crioprotector de varios compuestos: glicerol,
dimetilsulfóxido, sacarosa -
 Sakane desarrolla la técnica para el secado desde el estado líquido (L-drying)
Sakane desarrolla la técnica para el secado desde el estado líquido (L-drying) -
 23 instituciones internacionales autorizadas para recibir material
23 instituciones internacionales autorizadas para recibir material
biológico con una patente de aplicación (Tratado de Budapest 1991)
Looking for a timeline maker?
Create timelines for projects, roadmaps, history, lessons, legal cases, and stories with Timetoast. Timetoast is a timeline maker for work, school, research, and stories.